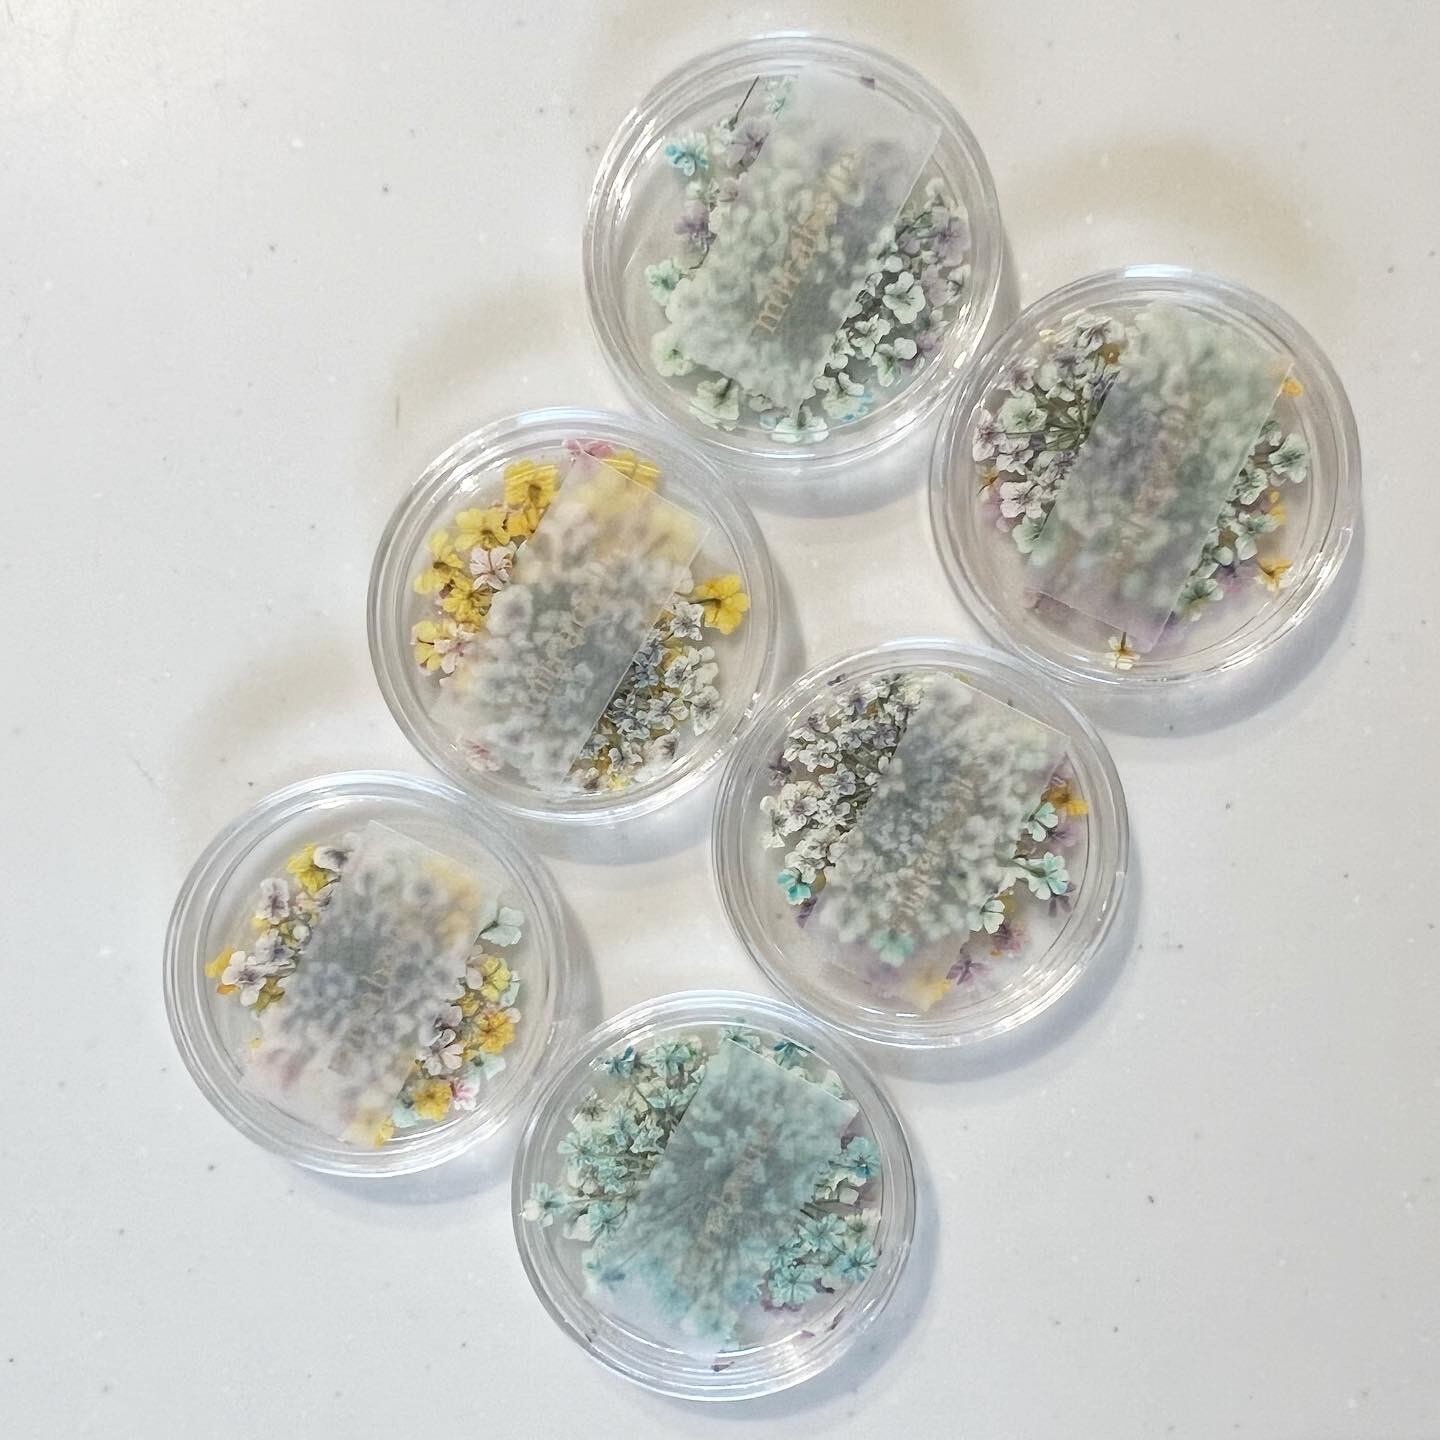

1/15
押し花【5枚セット】
¥770 税込
SOLD OUT
別途送料がかかります。送料を確認する
***2022年ver***
オリジナルで染色した押し花です。
【SALE】
990円→→→770円
お裾分け販売のため数に限りがあり、
どのセットも少しだけの販売です*
写真にある約直径3cmのケースに入れて
お届けします*
割と大きめなものが多いです。
使いやすいカラーに染色しました。
お花は自然なものなので大きさや形、
色づきにはバラつきがあります。
ドライフラワーはとても繊細で、
花びらが欠けていることもあります。
どうぞご了承の上でご購入下さいませ。
【各色の内容量】
・ピンク系*5枚
・ブルー系*5枚
・イエロー系5枚
・カラフル詰め合わせ*5枚
〈どの組み合わせかはランダムです〉
例〉14&15枚目の画像をご参照ください。
およそのサイズ感は
メジャーの映った写真にてご確認ください。
【ご購入にあたっての注意事項】
●色味などイメージとの相違や、お客様都合による返品はご遠慮ください。左と右のお間違えには十分お気をつけください。
●強い力を加えたりしないようご注意ください。
●全て手作業で作成しているため形や寸法に違いが生じることがあります。
●お使いの端末や閲覧環境により写真と実物の色味が多少異なって見えることがございます。
●配送時に花びらが欠けてしまうことも考えられます。
-
レビュー
(5)
-
送料・配送方法について
-
お支払い方法について
¥770 税込
SOLD OUT
最近チェックした商品
同じカテゴリの商品
その他の商品